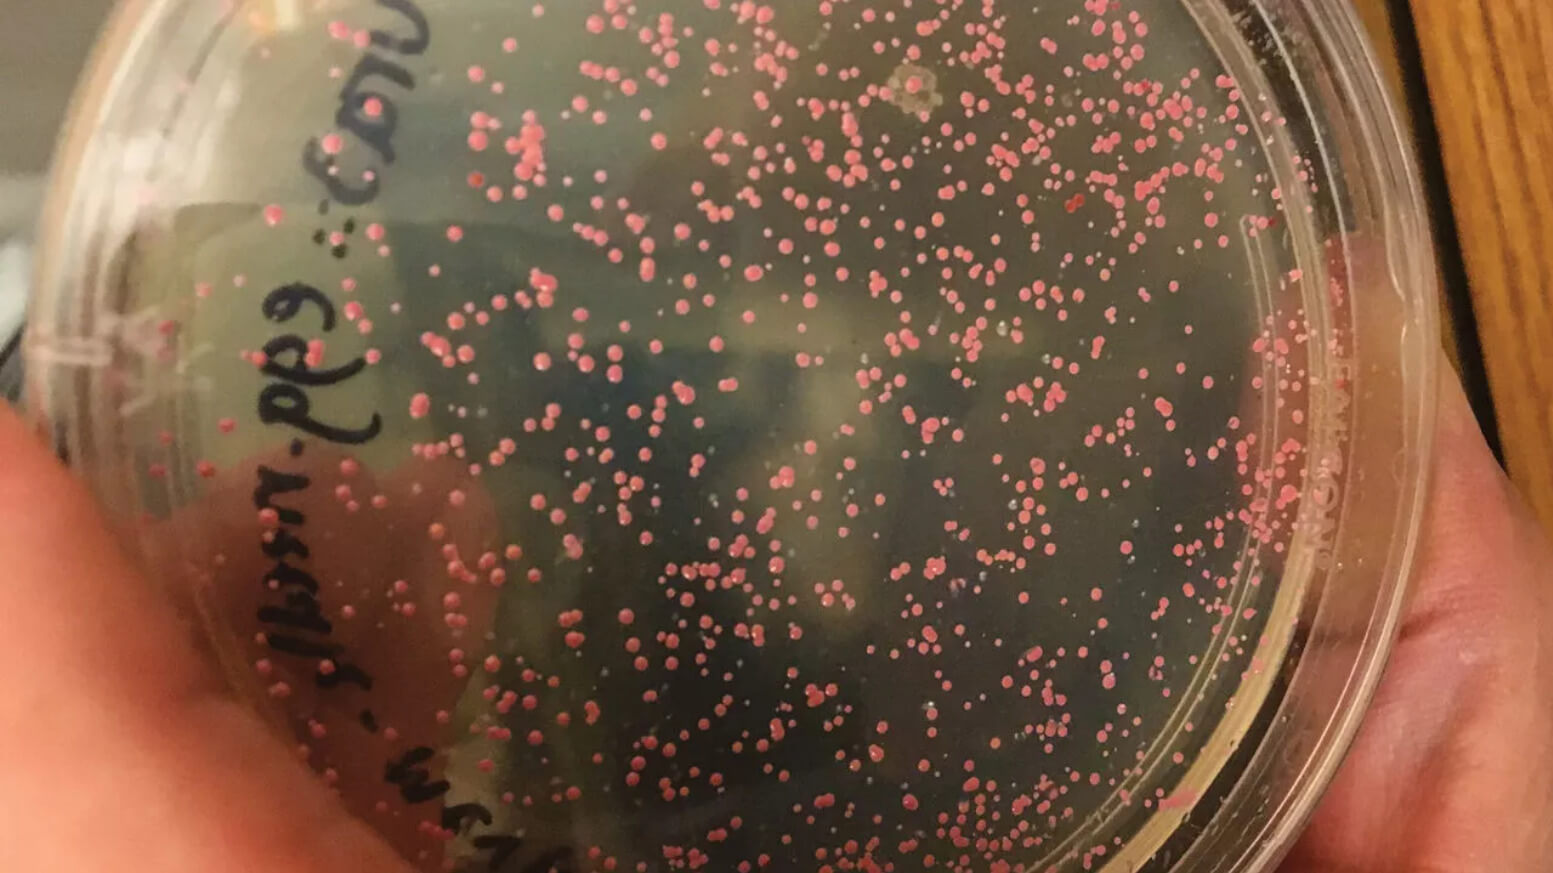

Micróbios de 100 milhões de anos são “ressuscitados” em laboratório
Microrganismos estavam em camadas sedimentares há uma década.
Por Rodrigo Duarte
A Agência Japonesa de Ciência e Tecnologia Terra-Marinha publicou recentemente um estudo no qual eles afirmam que conseguiram “ressucitar” microrganismos que teriam mais de 100 milhões de anos. De acordo com as informações que foram divulgadas pela agência, os organismos foram coletados há cerca de uma década no sistema de correntes marítimas Giro do Pacífico Sul, uma região com menor produtividade e nutrientes e onde a vida é rara.
“Nossa principal pergunta era se a vida poderia existir em um ambiente com poucos nutrientes ou se essa era uma zona sem vida”, disse Yuki Morono, líder do estudo, em declaração. “E queríamos saber quanto tempo os micróbios poderiam sustentar sua vida quase sem comida.”
Os cientistas japoneses perfuraram núcleos de sedimento por cerca de 100 metros que estavam a quase 6 mil metros abaixo da superfície do mar. Eles descobriram que existia oxigênio em todas as regiões exploradas, e que ele poderia chegar em determinadas camadas, caso ela se acumulasse lentamente.
Algumas amostras de microrganismos que foram encontrados acabaram sendo mantidas em incubadoras e alimentados ao longo de um período. E, para a grande surpresa dos pesquisadores, a grande maioria ainda estava vivo.

“No começo eu estava cético, mas descobrimos que até 99,1% dos micróbios em sedimentos depositados 101,5 milhões de anos atrás ainda estavam vivos e prontos para comer”, contou Morono.
Agora, os pesquisadores querem aplicar este mesmo tipo de abordagem em outros estudos geológicos, tentando encontrar mais comportamentos como este na natureza. Os pesquisadores destacam que a vida desses microrganismos é muito mais lenta do que a nossa, portanto acaba tendo uma velocidade evolutiva menor também. Mesmo assim, a pesquisa mostra que o fundo do oceano pode acabar se tornando um excelente local para explorar e entende os limites da vida no planeta Terra.

O que o chocolate tem de bom?
Você sabia que existe o Dia do Silêncio?
Por que existe horário de verão?
5 curiosidades sobre a rainha Elizabeth II
Ano Novo: como surgiu?